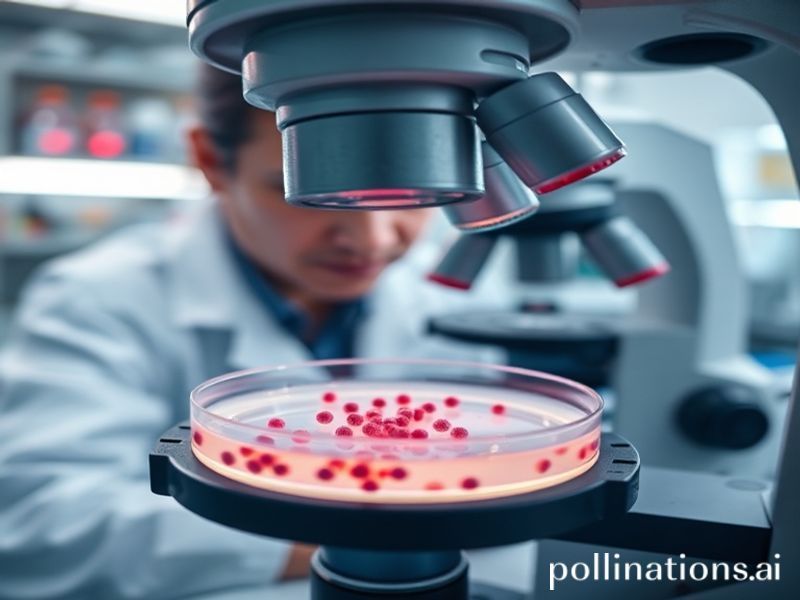
Trending: adenovirus disease

Adenovirus: The Uninvited Guest Crashing the Global Party
Adenovirus: The Uninvited Guest Crashing the Global Party
Alright, folks, buckle up! We’re diving into the world of adenoviruses, the uninvited guests that have been crashing the global party lately. You might be thinking, “Adena-what-now?” or “Is this another Zoom background trend?” Nope, it’s a real thing, and it’s been making waves worldwide. So, grab your metaphorical masks, and let’s get into it.
What’s the Buzz?
Adenoviruses are a group of viruses that can cause a range of illnesses, from the common cold to more severe diseases like pneumonia and conjunctivitis. They’re not new—scientists have known about them since the 1950s. But why are they trending now? Well, thanks to the internet and global news cycles, we’re more connected than ever, and information (and misinformation) spreads faster than a sneeze in a wind tunnel.
Cultural Context: The Plot Thickens
Imagine this: It’s 2020, the world is still reeling from the COVID-19 pandemic, and suddenly, reports of adenovirus outbreaks start popping up. In the U.S., there’s a surge in cases among children, particularly those with weakened immune systems. In Europe, there are reports of outbreaks in schools and daycare centers. Meanwhile, in Asia, health officials are on high alert, monitoring the situation closely.
But here’s the twist: adenoviruses are seasonal. They tend to peak in the winter and spring, much like the flu. So, is this just a case of “it’s that time of year again,” or is there something more sinister at play? Enter the internet, stage left.
Social Impact: The Meme Machine
In the age of memes and misinformation, adenoviruses have become the latest topic of discussion (and debate) on social media. Some people are sharing personal stories of illness, while others are spreading (pun intended) conspiracy theories about the virus’s origins. Meanwhile, health officials are scrambling to set the record straight, reminding everyone that adenoviruses are not new, and there’s no need to panic.
But let’s not forget the silver lining. The increased awareness about adenoviruses has also led to a surge in discussions about public health, hygiene, and the importance of vaccination. It’s a reminder that even in the face of a global health crisis, there’s always an opportunity to learn and grow.
Why Should You Care?
You might be thinking, “Okay, but why should I care about adenoviruses?” Well, for starters, they’re a reminder that the world of viruses is vast and complex. Just because we’ve weathered one storm (COVID-19) doesn’t mean we’re out of the woods yet. Adenoviruses are a reminder to stay vigilant, practice good hygiene, and support public health efforts.
Moreover, adenoviruses are a testament to the power of the internet. In a world where information spreads faster than a virus, it’s more important than ever to be informed, critical thinkers. So, the next time you see a headline about adenoviruses, don’t just scroll past. Take a moment to read, learn, and engage.
Conclusion: The Plot Twist
So, there you have it, folks. Adenoviruses: the uninvited guests that have been crashing the global party. They’re a reminder that the world of viruses is complex, that the internet is a powerful tool, and that we’re all in this together. So, let’s roll up our sleeves, wash our hands, and face the future with courage, curiosity, and a healthy dose of humor.
After all, if we can’t laugh in the face of adversity, what’s the point of having the internet, right?